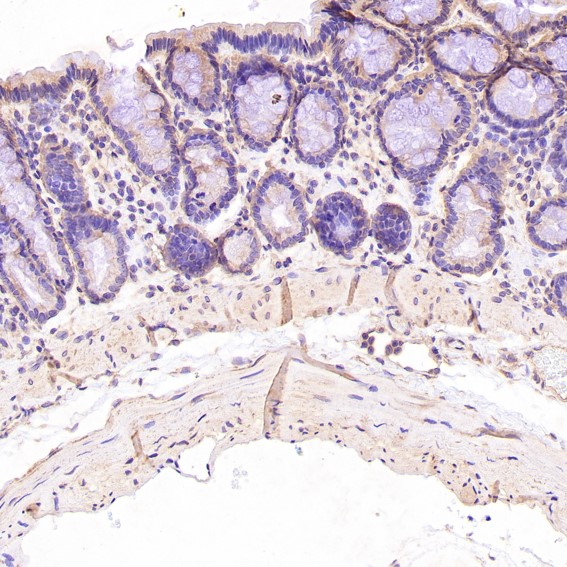
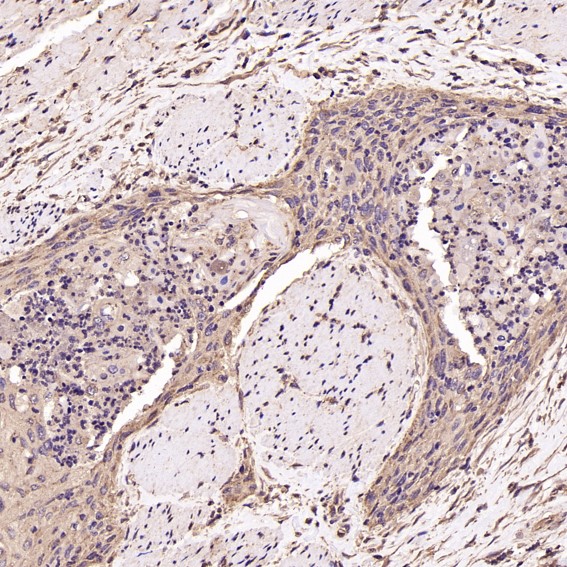

| Western blot (WB): | 1:500-2000 |
| Immunohistochemistry (IHC): | 1:50-200 |
| Immunocytochemistry/Immunofluorescence (ICC/IF): | 1:50-200 |

Western blot analysis of extracts of Human cerebellum lysate, using BDNF antibody.

All lanes use the Antibody for 1 hour at room temperature.

Immunohistochemical analysis of paraffin-embedded Rat stomach, using the Antibody.

Immunohistochemical analysis of paraffin-embedded Rat pancreas, using the Antibody.

Immunohistochemical analysis of paraffin-embedded Mouse heart, using the Antibody.

Immunohistochemical analysis of paraffin-embedded human testis, using BDNF Antibody .

Immunohistochemical analysis of paraffin-embedded Human lung, using the Antibody.

Immunohistochemical analysis of paraffin-embedded Human esophageal carcinoma, using the Antibody.

Immunofluorescent analysis using the Antibody.

Immunofluorescent analysis of HeLa cells, using BDNF Antibody.

Western blot analysis of extracts of Human cerebellum lysate, using BDNF antibody.

All lanes use the Antibody for 1 hour at room temperature.

Immunohistochemical analysis of paraffin-embedded Rat stomach, using the Antibody.

Immunohistochemical analysis of paraffin-embedded Rat pancreas, using the Antibody.

Immunohistochemical analysis of paraffin-embedded Mouse heart, using the Antibody.

Immunohistochemical analysis of paraffin-embedded human testis, using BDNF Antibody .

Immunohistochemical analysis of paraffin-embedded Human lung, using the Antibody.

Immunohistochemical analysis of paraffin-embedded Human esophageal carcinoma, using the Antibody.

Immunofluorescent analysis using the Antibody.

Immunofluorescent analysis of HeLa cells, using BDNF Antibody.